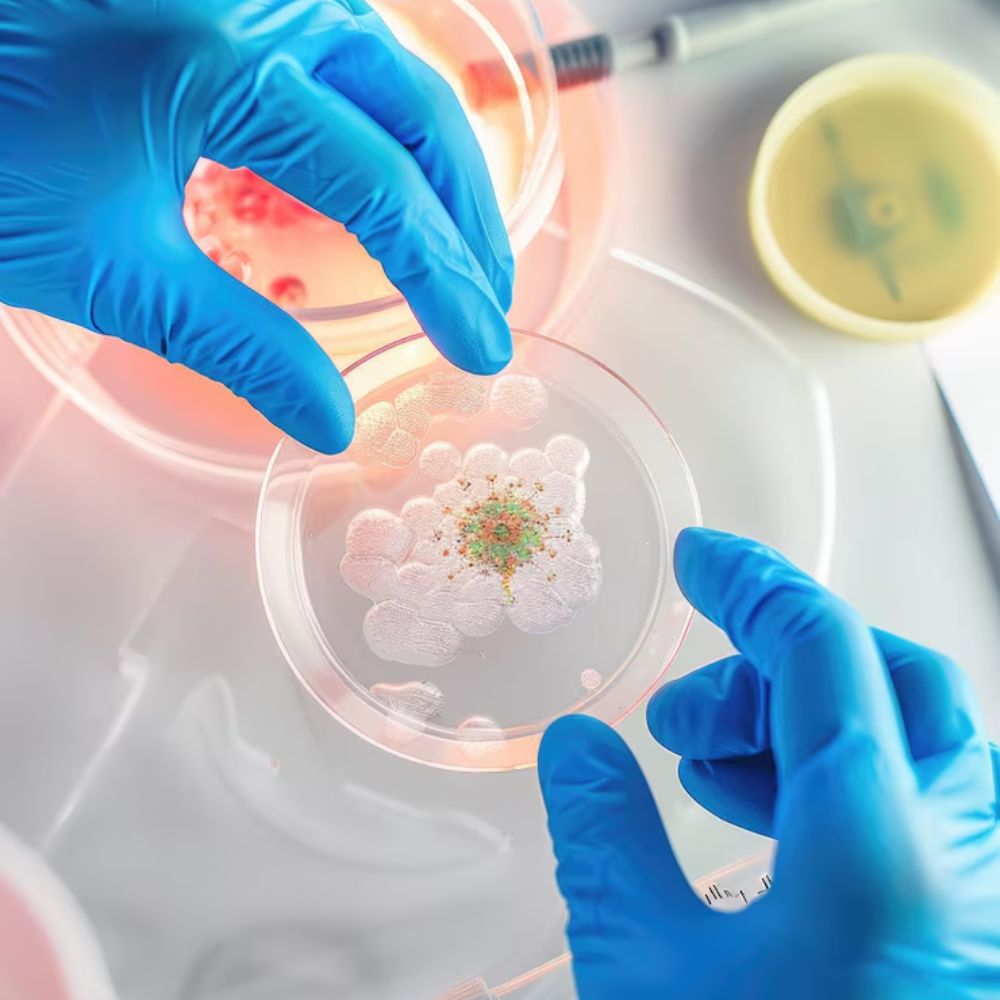

Sexual Wellness Miami: A Complete Guide to Better Health and Confidence at Nexxis BioHealth
By Nexis BioHealth
Sexual health is a key part of your overall well-being, confidence, and quality of life. However, many individuals delay seeking help due to discomfort or the belief that these issues are a normal part of aging.
At Nexsis BioHealth in Miami, sexual wellness is approached differently. Instead of temporary solutions, we focus on regenerative, medically guided treatments that target the root causes of sexual health concerns helping you restore function, vitality, and confidence.


What Is Sexual Wellness?
Sexual wellness is more than just performance. It includes:
- Healthy libido and desire
- Strong and consistent function
- Sensitivity and responsiveness
- Emotional confidence and intimacy
At Nexsis BioHealth, we understand that sexual health is influenced by multiple factors, including:
- Reduced blood flow
- Tissue degeneration
- Hormonal changes
- Stress and lifestyle factors
Our approach focuses on identifying and treating these underlying causes.
Common Sexual Health Concerns We Treat
At our Miami clinic, patients commonly seek care for:
- Erectile dysfunction (ED)
- Low libido
- Reduced sensitivity
- Fatigue and low energy
- Performance-related concerns
These conditions are often linked to circulatory and tissue health issues, which can be addressed through advanced regenerative therapies.
Our Advanced Approach to Sexual Wellness in Miami
At Nexsis BioHealth, we specialize in stem cell therapy for sexual wellness, offering one
of the most advanced solutions available today.

Stem Cell Therapy (Regenerative Medicine)
We use Mesenchymal Stem Cells (MSCs) to help restore sexual function at a cellular level. This therapy works by:
- Regenerating damaged tissues to improve function
- Enhancing blood flow through new vessel formation (angiogenesis)
Reducing inflammation that may interfere with performance
Unlike medications, this approach focuses on long-term restoration, not short-term results.
Stem Cell Therapy for Erectile Dysfunction in Miami
Erectile dysfunction is often caused by poor circulation or tissue damage. Our regenerative treatments are designed to address these issues directly.
Patients may experience:
- Improved erection quality and duration
- Increased sensitivity and responsiveness
- Enhanced performance
- Greater confidence and satisfaction


A Personalized, Physician-Guided Experience
Every patient at Nexsis BioHealth receives a customized treatment plan based on:
- Medical history
- Current symptoms
- Individual goals
Your care begins with a comprehensive consultation, ensuring that your treatment is tailored specifically to your needs.
We provide all services in a discreet, professional, and supportive environment.
Sexual Wellness as Part of Longevity Care
At Nexsis BioHealth, sexual wellness is not treated as an isolated concern—it is part of a broader focus on long-term health, vitality, and performance.
Improving sexual health can lead to:
- Increased confidence
- Better emotional well-being
- Stronger relationships
- Improved overall quality of life


What to Expect at Nexsis Bio Health
At Nexsis BioHealth, sexual wellness is not treated as an isolated concern—it is part of a broader focus on long-term health, vitality, and performance.
Improving sexual health can lead to:
- Increased confidence
- Better emotional well-being
- Stronger relationships
- Improved overall quality of life
Our goal is to provide safe, effective, and medically guided solutions that deliver lasting results.
Start Your Journey to Better Sexual Health in Miami
If you’re experiencing changes in performance, confidence, or energy, you don’t have to accept it as normal.
At Nexsis Bio Health in Miami, we help you take a proactive approach to your sexual health with advanced regenerative treatments designed for real, lasting improvement.
